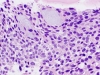

MALIGNANT: Other (Mucoepidermoid carcinoma of the thyroid)
|
|
|

Tumor cells exhibit squamous differentiation with keratin formation (ThinPrep).
|
|

Some tumor cells appear glandular, with granular cytoplasm, round nuclei, and prominent nucleoli (ThinPrep).
|
|

Intermediate-type cells and small keratin pearls (ThinPrep).
|
|

Small pearl (ThinPrep).
|
|

Intermediate-type cells and occasional small keratin pearl (ThinPrep).
|
|

Glandular-type cells and occasional eosinophils (ThinPrep).
|
|

Large keratin pearl (ThinPrep).
|
|
Histologic section.
|
|

Histologic section.
|
|

Histologic section.
|
|

Histologic section.
|
|

Histologic section.
|
|
|
|